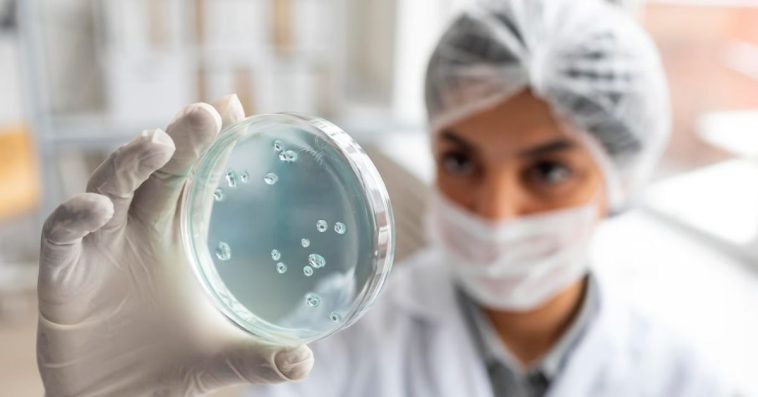
legionella gdzie w polsce

Do 127 wzrosła liczba osób zakażonych Legionellą. W ostatniej dobie przybyło więc 14 kolejnych przypadków. Niestety kolejną niepokojącą informacją jest to, że bakteria wyszła poza woj. podkarpackie i pojawiła się w kolejnym województwie.
Legionella. Gdzie w Polsce chorują? Pierwszy przypadek w województwie lubelskim
Wśród hospitalizowanych jest mieszkaniec województwa lubelskiego, co oznacza, że bakteria pojawiła się w kolejnym województwie. Według informacji PAP zakażony Legionellą mężczyzna przyjęty do szpitala w Lublinie przebywał wcześniej na terenie Podkarpacia.
Służby sanitarne z Lubelskiego rozpoczęły monitoring wszystkich ujęć wody i wody w wodociągach po wystąpieniu zakażeń bakterią legionella w Rzeszowie. Źródłem zakażenia jest najprawdopodobniej skażona woda pochodząca z miejskiego wodociągu w Rzeszowie. Wodociąg w ten weekend ma być dezynfekowany.
Od czasu potwierdzenia zakażeń Legionellą w województwie podkarpackim, na terenie województwa lubelskiego prowadzony jest ścisły monitoring jakości wody w sieciach wodociągowych.https://t.co/j5onQXXH9X
— Urząd Wojewódzki (@LUWLublin) August 26, 2023
Od początku wystąpienia ogniska choroby na Podkarpaciu zakażeniu uległo już 127 pacjentów. Oficjalnie mówi się o 8 osobach, które zmarły z powodu Legionelli, choć pojawiły się w mediach doniesienia o 9 ofierze. Zmarli to na pewno 5 mężczyzn oraz 3 kobiety. Wszyscy mieszkali w Rzeszowie lub na terenie powiatu rzeszowskiego.